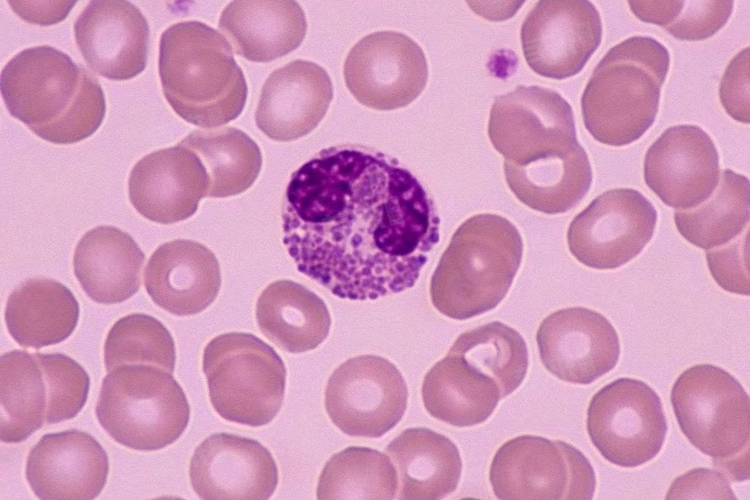

白细胞计数偏高可能由多种原因引起,需要结合临床症状、其他检查结果以及病史进行综合判断,以便于针对病因采取针对性措施。
1、剧烈运动:
剧烈运动时身体的能量需求增加,代谢产物增多,为应对这种情况,免疫系统会被激活,导致白细胞迅速从储存部位释放到血液循环中,从而使白细胞计数暂时升高。
2、应激状态:
强烈的情绪反应会触发神经内分泌系统的应激反应,促使体内释放多种激素,如肾上腺素、皮质醇等,上述激素可以刺激骨髓释放更多的白细胞进入血液循环。
3、妊娠:
在妊娠后期孕妇体内的激素水平发生变化,免疫系统也会相应调整以适应胎儿的生长和发育,同时分娩过程中的应激和身体的损伤修复需求也会导致白细胞计数轻度增加。
4、药物反应:
如糖皮质激素具有抗炎和免疫抑制作用,但同时也可以刺激骨髓造血,导致白细胞计数升高;儿茶酚胺类药物如肾上腺素可以促使边缘池的白细胞进入循环池,使白细胞计数暂时升高。
5、感染:
当身体受到病原体入侵时,免疫系统会启动防御机制,白细胞是主要的免疫细胞,会迅速增殖并向感染部位聚集,以消灭病原体,从而导致白细胞计数升高。细菌感染时白细胞中的中性粒细胞通常会显著增多,病毒感染时淋巴细胞增多较为常见。
6、炎症:
自身免疫性炎症疾病中,免疫系统错误地攻击自身组织,引发炎症反应。为应对这种持续的炎症刺激,白细胞会不断增生和活化,导致白细胞计数升高。
7、内分泌疾病:
甲状腺危象时甲状腺激素大量释放,机体代谢亢进,应激反应增强,可导致白细胞计数升高。而肾上腺皮质功能亢进症时,皮质醇分泌过多,也可能影响白细胞的分布和生成,导致白细胞计数升高。
8、组织损伤:
严重的外伤、烧伤或手术创伤会导致大量组织细胞坏死,上述坏死物质会吸引白细胞聚集并引发炎症反应,以清除坏死组织和促进修复,从而导致白细胞计数升高。
9、恶性肿瘤:
白血病、淋巴瘤等恶性肿瘤细胞本身具有无限增殖的能力,会大量产生白细胞,导致白细胞计数异常升高。此外,肿瘤组织的坏死和继发感染也可能刺激白细胞增多。
建议保证充足的睡眠,避免过度劳累,以利于身体的恢复和免疫系统的调节,适当减少活动量,尤其是在白细胞计数偏高且伴有明显症状时。摄入富含蛋白质、维生素、矿物质等营养物质的食物,如瘦肉、鱼类、蛋类、新鲜蔬菜和水果等,以增强机体抵抗力。建议定期进行血常规检查,监测白细胞计数的变化。

